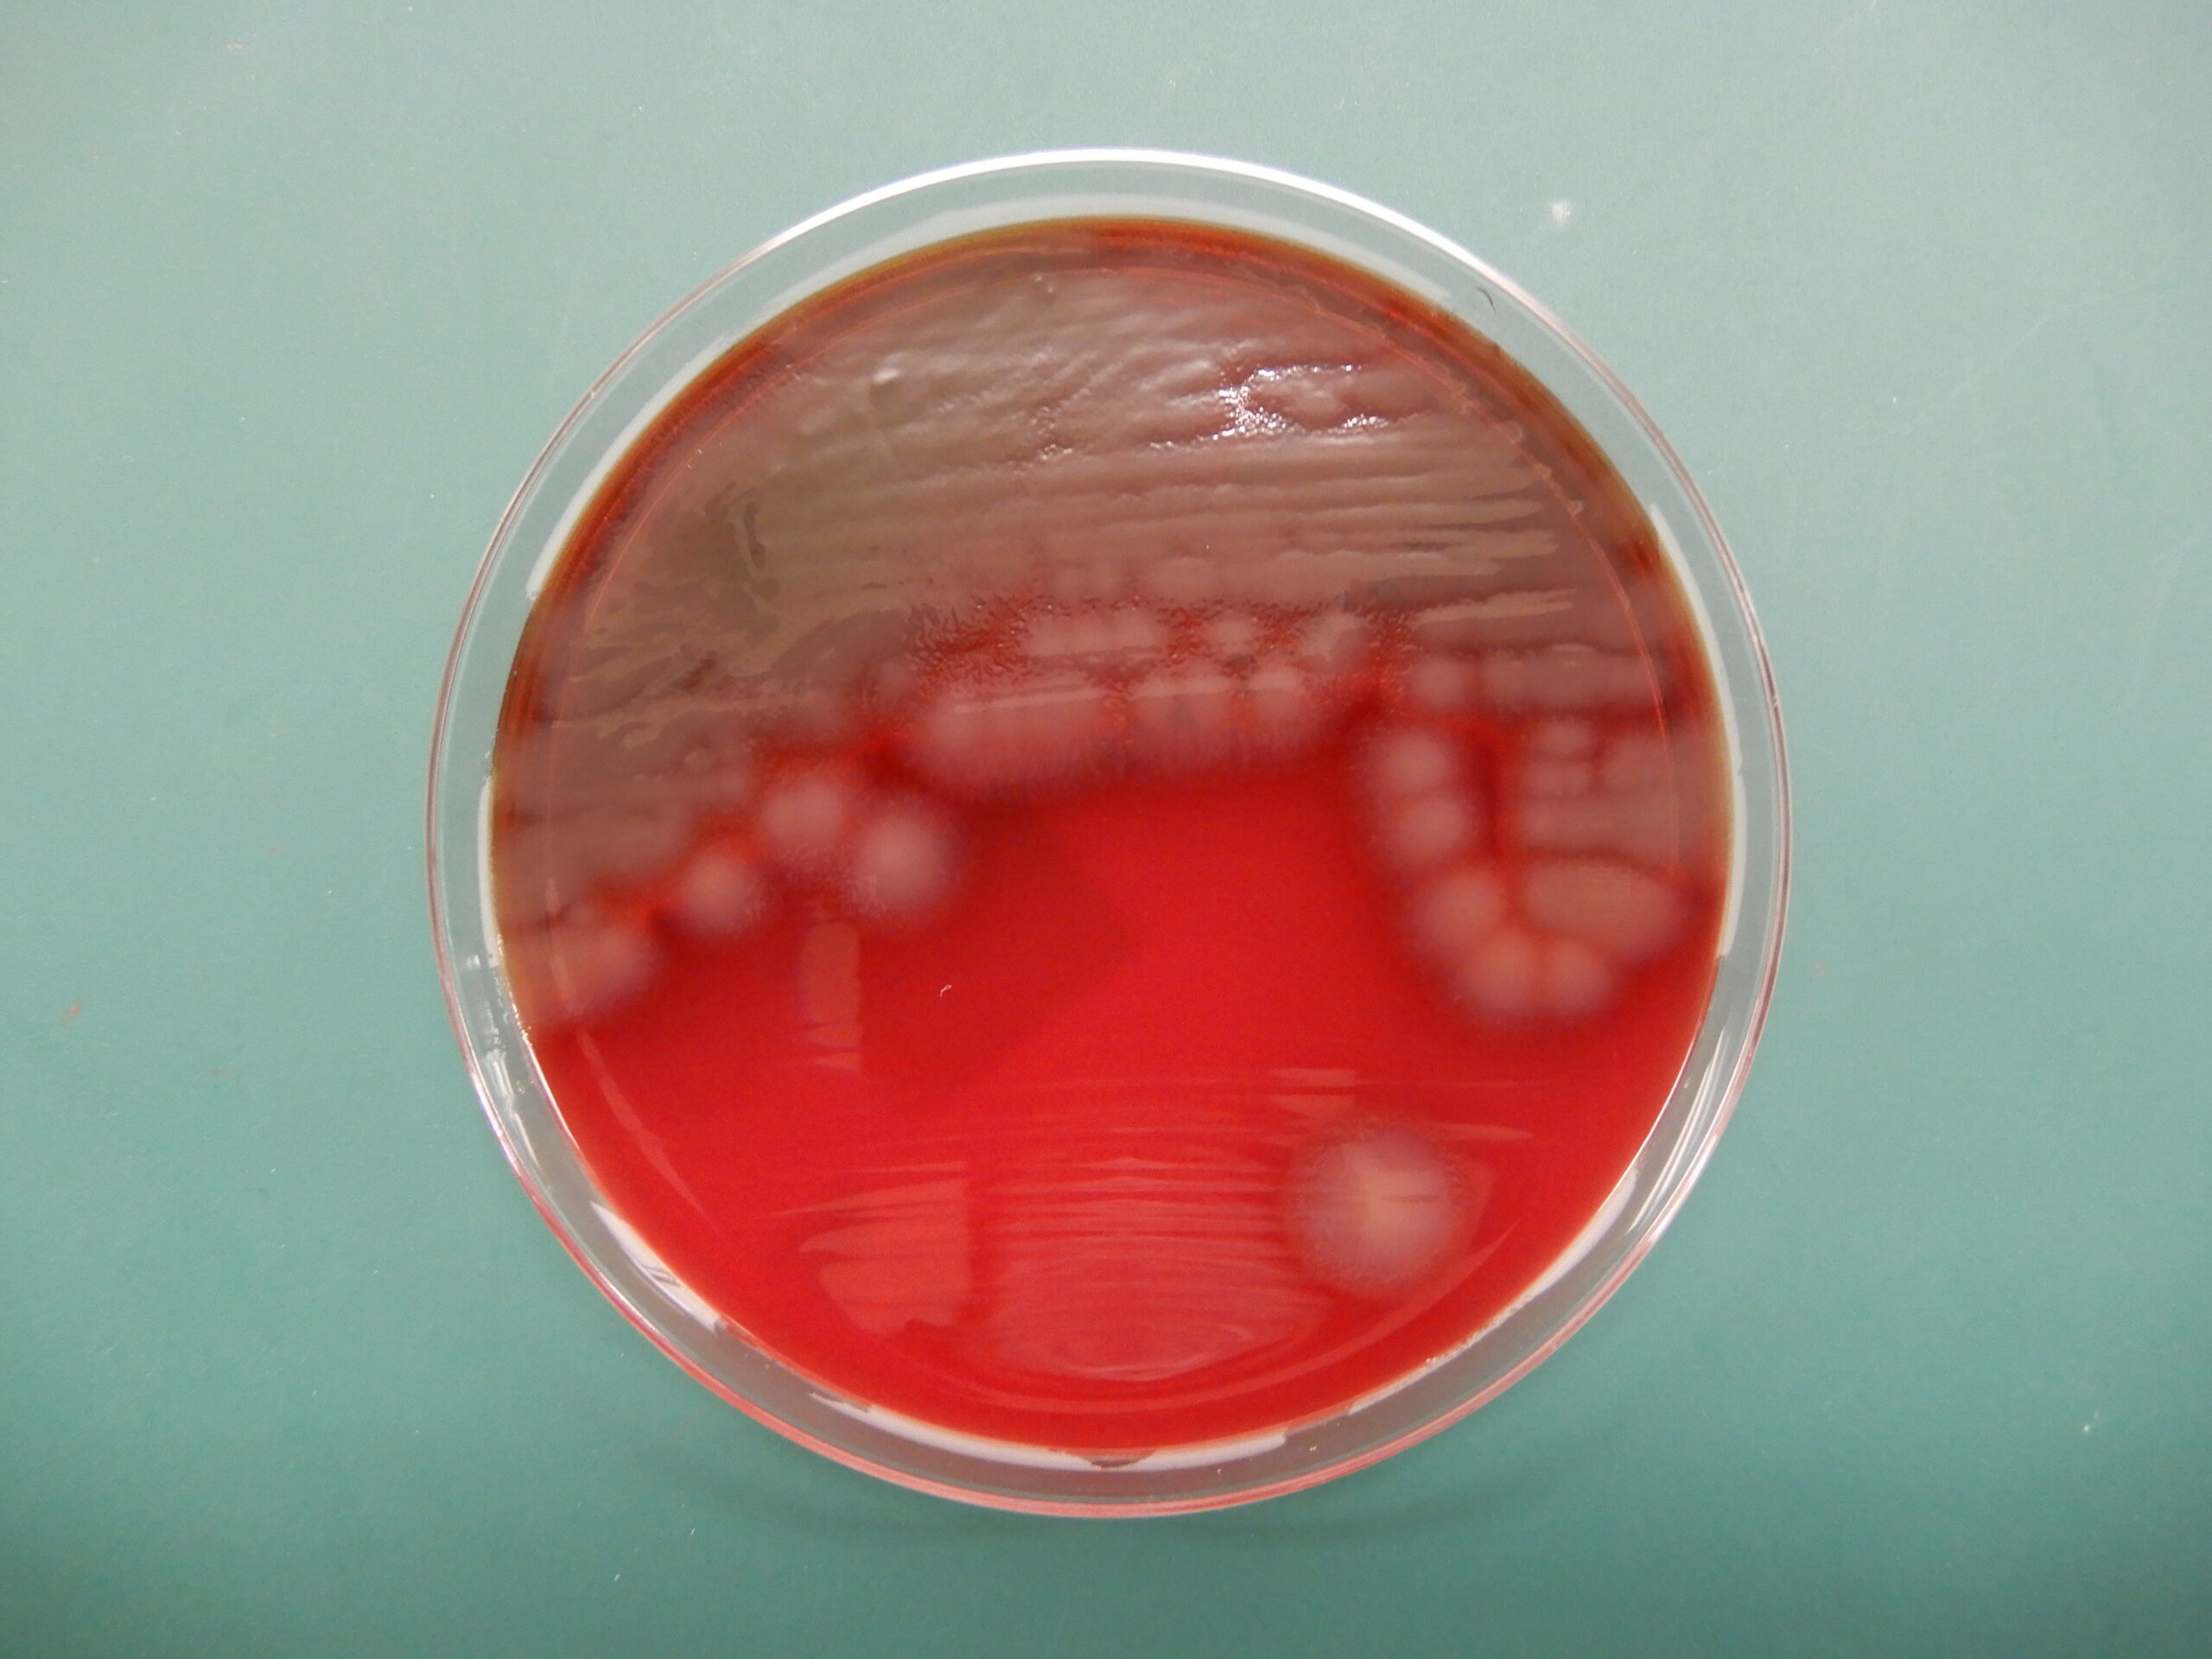
妊娠中の検査

嚢胞性線維症のある人の中には妊娠が難しい人もいますが、それでも妊娠することは可能です。また、妊娠糖尿病や低出生体重児などの合併症のリスクも高くなります。
嚢胞性線維症(CF)は、男性と女性の両方の生殖能力に影響を与えます。自然に妊娠できる人もいますが、体外受精(IVF)などの不妊治療が必要な人もいます。
CF を持つことには特有の課題があり、産みの親と乳児の両方の健康に影響を与える可能性があります。したがって、妊娠の複雑さを乗り越えるには、慎重な計画と医療サポートが必要です。
この記事では、潜在的なリスクや安全で妊娠を成功させるためのヒントなど、嚢胞性線維症を抱えながら妊娠している人に影響を与える要因を探ります。
性別と性別に関するメモ
セックスとジェンダーはスペクトル上に存在します。この記事では、出生時に割り当てられた性別を指すために「男性」、「女性」、またはその両方という用語を使用します。詳細については、ここをクリックしてください。
CF は男性と女性の両方の生殖能力に悪影響を与える可能性があります。これは、女性は妊娠するのがより困難である可能性があり、男性はパートナーを妊娠させるのがより困難である可能性があることを意味します。
CF の女性の多くは健康な卵子を産み、不妊治療なしで妊娠することができます。ただし、CF のない人よりも妊娠しにくいと感じる可能性があります。
まず、CF の女性は、病気や低体重のために月経周期が不規則になったり、月経周期がなくなったりする可能性が高くなります。第二に、CF は頸管粘液を濃くし、精子が卵子に到達するのを妨げる可能性があります。
CF を持つ男性の 98% 以上が、精子の輸送の問題により生殖能力に問題を抱えています。精管(精子を尿道に運ぶ管)の欠損または欠損は、精液に精子が含まれていない可能性があることを意味します。
CF による不妊症と不妊治療の選択肢について詳しく学びましょう。
CFのある人の妊娠は、そうでない人よりも難しいかもしれませんが、この疾患を持つ人の多くは、自然に、または不妊治療の助けを借りて妊娠することができます。
特定の妊娠ガイドラインに従うことは、CF 患者が健康で成功した妊娠をするのに役立ちます。以下の推奨事項は、親と胎児の健康を最適化することを目的としています。
- 妊娠前の計画:妊娠する前に、潜在的なリスクと健康を改善するために必要な手順について医療チームに相談する必要があります。
- 肺機能:理想的には、妊娠前に努力呼気量 (FEV1) が 50% 以上測定される必要があります。 FEV1 値の低下と合併症のリスクの増加との間には関連性があります。
- 定期的な出生前ケア:これらの予約により、医療チームは患者の肺機能、栄養状態、妊娠糖尿病などの妊娠の問題を監視することができます。また、詳細な出生計画を立てるのにも役立ちます。
- 薬の管理:医療チームと協力して現在の薬を見直し、妊娠中および産後の薬が安全であることを確認する必要があります。
- 栄養サポート:妊娠中は適切な栄養を維持することが重要です。妊娠により増加する栄養要求を満たすために、追加のカロリー摂取、ビタミンの補給、栄養士のサポートが必要になる場合があります。
- 産後のケア:出産後も、赤ちゃんの健康状態だけでなく、回復、肺機能、全体的な健康状態を監視するために、引き続き綿密な医学的監督を受ける必要があります。
CF と同居中に妊娠すると、産みの親と赤ちゃんの両方に影響を与える可能性のあるいくつかのリスクと合併症が発生します。これらには次のものが含まれます。
- 呼吸器合併症:妊娠による呼吸需要の増加は肺機能に影響を与え、感染症のリスクを高める可能性があります。
- 栄養面の課題: CF により、最適な栄養を維持することが困難になります。したがって、妊娠により増加する栄養要求を満たすために食事サポートが必要になる場合があります。
- 妊娠糖尿病: CF の女性は、妊娠中に妊娠糖尿病を発症する可能性が高くなります。これは、新生児の高出生体重、早産、呼吸困難などの合併症を引き起こす可能性があります。
- 早産と早産: CF は早産と早産のリスクを高め、新生児に呼吸困難、臓器の未発達、長期的な健康問題を引き起こす可能性があります。
- 低出生体重児:母親の栄養失調やその他の妊娠合併症により、乳児の出生体重が低くなることがあります。出生体重が低いと、摂食が困難になり、成長が遅くなり、感染症にかかりやすくなります。
- 薬剤に関連した合併症: CF を管理する一部の薬剤は、妊娠中に安全ではない可能性があります。
CF 患者が妊娠している場合、医療チームは定期的な検査と評価を実施して、本人と胎児の両方が健康であることを確認します。
これらには次のものが含まれる場合があります。
- 肺機能検査
- バークホルデリア・セパシア感染検査
- 栄養状態
- 肝臓と腎臓の機能検査
- メンタルヘルス検査
- 妊娠糖尿病のモニタリング
赤ちゃんにCFが感染しているかどうかを確認するための検査を受けることもあります。
赤ちゃんがCFの可能性があるかどうかを示すことができる2つの出生前検査:
- 絨毛膜絨毛サンプリング (CVS):これには、妊娠 10 週から 13 週の間に胎盤組織のサンプルを採取することが含まれます。
- 羊水穿刺:これには、妊娠 15 週目から 20 週目までの間に、赤ちゃんを取り囲む羊水のサンプルを採取することが含まれます。
妊娠中に特別な注意を払うことで、最良の結果が得られます。最初に必ず医師に相談する必要がありますが、次のヒントを考慮すると役立つ場合があります。
- 定期的な出生前診察に参加する:定期的な健康診断により、健康状態を適切にモニタリングし、既存の健康上の問題を管理することができます。
- 適切な栄養を維持する:十分な量を食べるのが難しい場合は、栄養補助食品を飲むことを検討してください。個別の推奨事項については、医療チームに相談する必要があります。
- ビタミンとミネラルのサプリメントを検討する:妊娠中にビタミンとミネラルのサプリメントを推奨しているかどうか、医療専門家に尋ねてください。
- 穏やかな運動でアクティブに過ごす:ウォーキングや水泳など、衝撃の少ない活動を定期的に行ってください。
- メンタルヘルスへのケア:必要に応じて、友人、家族、メンタルヘルスの専門家にサポートを求め、感情的な懸念に対処します。
妊娠について医師に相談するときは、次の質問をすると役立つかもしれません。
- CF は私の妊娠と赤ちゃんの健康にどのような影響を及ぼしますか?
- 妊娠を試みる前または妊娠中に受けるべき特別な検査やスクリーニングはありますか?
- CF ヘルスケア チームおよび産科医との出生前予約はどれくらいの頻度で計画すればよいですか?
- 妊娠中に服用を中止したり調整したりする必要がある薬はありますか?
- 妊娠に伴う増大する需要に確実に対応するために推奨される栄養計画は何ですか?
- 私の CF は私の母乳育児能力にどのような影響を及ぼしますか?
妊娠するのはより困難になる可能性がありますが、CF 患者は自然に妊娠することも、不妊治療の助けを借りて妊娠することもできます。医療チームと緊密に連携し、その指導に従うことで、人々は妊娠と出産を成功させることができます。
適切な栄養を優先し、穏やかな運動をし、既存の健康状態を管理し、定期的に出生前訪問を受けることは、健康な妊娠に不可欠です。
可能な限り最良の結果を確実に得るために、プロセス全体を通じて質問し、サポートを求め、常に最新情報を入手してください。
嚢胞性線維症を抱えながら妊娠する場合に知っておくべきこと・関連動画
参考文献一覧
- https://www.ncbi.nlm.nih.gov/pmc/articles/PMC9963833/
- https://www.cff.org/managing-cf/planning-safe-pregnancy#:~:text=肺%20機能%3A%20理想的に%2C%20a%20人、%20健康%20of%20あなたの%20新生児。
- https://www.cysticfibrosisjournal.com/article/S1569-1993(19)30839-2/fulltext
- https://www.acog.org/womens-health/faqs/cystic-fibrosis-prenatal-screening-and-diagnosis#:~:text=Chorionic%20Villus%20Sampling%20(CVS)%3A,or%20cause% 20of%20a%20病気。
- https://www.cysticfibrosis.org.uk/what-is-cystic-fibrosis/how-does-cystic-fibrosis-affect-the-body/symptoms-of-cystic-fibrosis/fertility